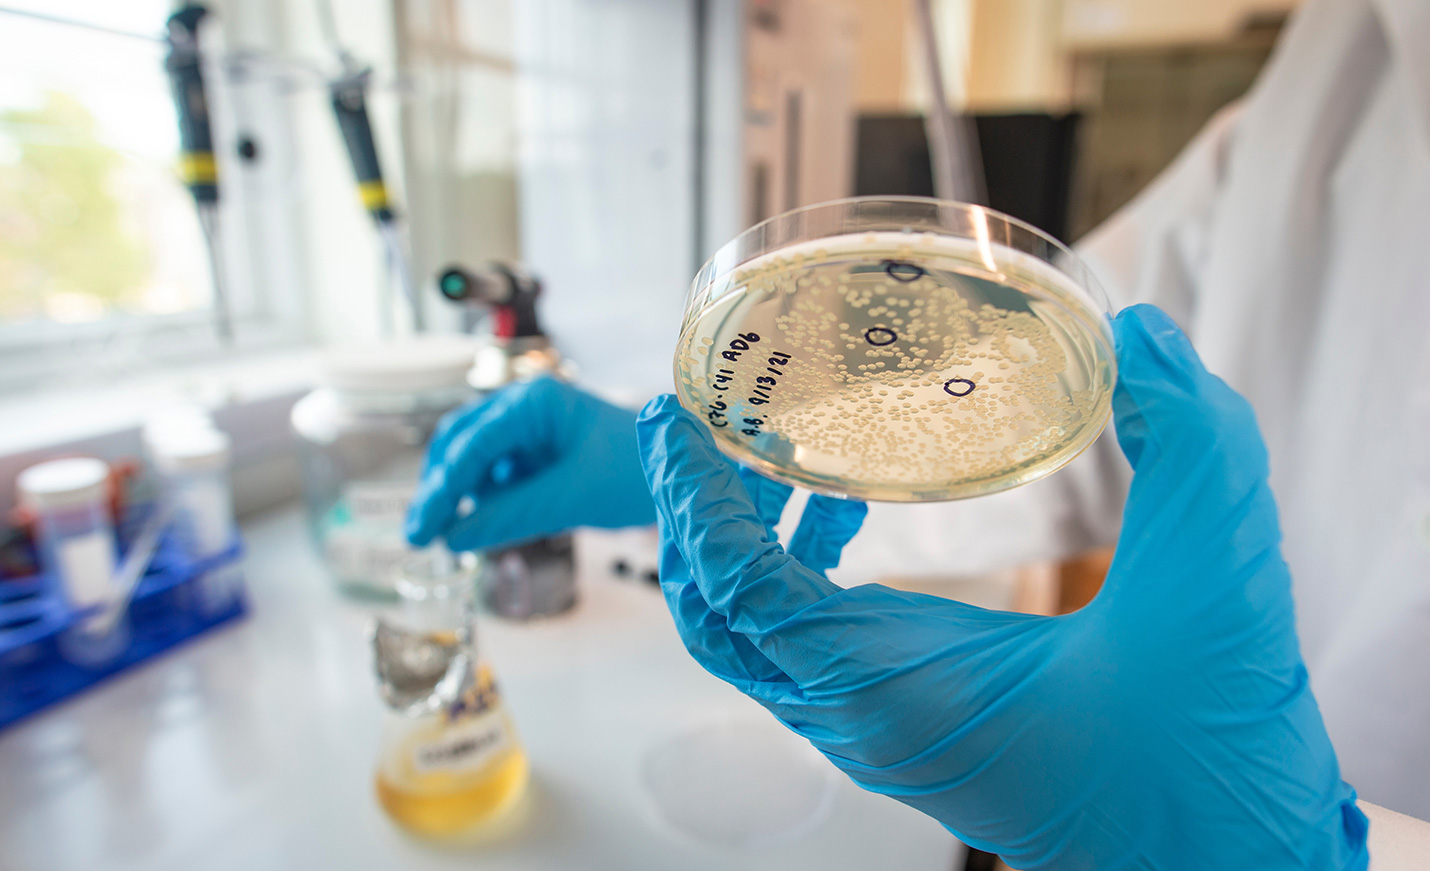

Chemistry, M.S.
The Chemistry M.S. is a research-focused program that will prepare you for further graduate school or a career in chemistry through mentored independent research and advanced coursework.
Chemistry (Online), M.S.
UNCW's online program deepens your knowledge of chemistry with extensive coursework, while also providing tracks in business, education, or clinical research to advance career goals.